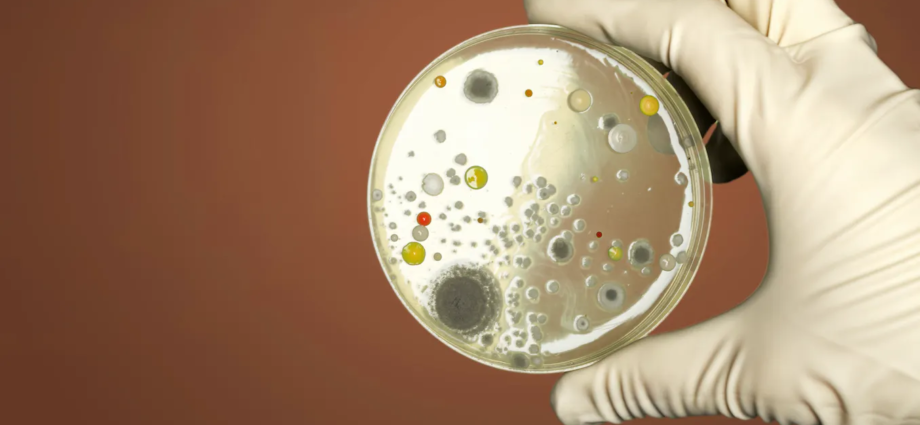

Laura Domínguez, Concordia University
December 11, 2023
Antimicrobial resistance (AMR) is one of the World Health Organization’s most urgent health challenges for the next decade. While AMR is a global threat, a tale of two worlds emerges, highlighting the heightened vulnerability of low- and middle-income countries (LMICs).
Misuse of antimicrobials worldwide has accelerated the evolution of antimicrobial resistance. For instance, in many countries, antibiotics are available over the counter, and even when their use is more regulated, the Centers for Disease Control has estimated that in the United States, one in three antibiotic prescriptions were unnecessary.
Likewise, most of the antibiotics are not even given to humans. As much as 80 per cent of the total consumption is used in livestock to promote growth, and to treat or prevent infections.
This has facilitated bacteria and other microorganisms to become resistant to the drugs that were once effective in treating them — sometimes called superbugs. This problem was associated with 4.95 million deaths worldwide in 2019.
A ‘silent pandemic’

If we don’t take action, things could get even worse. Reports predict that by 2050, AMR could cause 10 million deaths each year and cost the world US$100 trillion.
Fortunately, many nations are now taking decisive steps toward controlling what the WHO calls a “silent pandemic.” Acknowledging the gravity of the situation, high-income countries (HICs) such as the U.S. and Canada have implemented robust plans encompassing surveillance, stewardship and policy reforms.
These efforts should undoubtedly be applauded. However, an important principle of the “One Health” approach, which is often neglected, is that this is a global problem, and global collaboration should be prioritized. Low- and middle-income countries bear a disproportionate burden of AMR and require increased resource mobilization, knowledge sharing and international co-operation.
Contrasting realities
As a doctoral researcher, I study the evolution of antimicrobial resistance in bacteria, but as an immigrant from Mexico, I am deeply concerned with the disparity observed between high-income and low- and middle-income countries, and their contrasting realities.

For instance, there have been great efforts in regulating antibiotic consumption in many HICs, where antibiotic use in livestock has decreased and antibiotics are only accessible under prescription. While there is still room for improvement, there is a less encouraging reality in some LMICs, where antibiotics are usually obtained easily without prescriptions and sometimes used as a way to compensate for the difficulty of accessing health-care professionals.
Likewise, in some LMICs, antibiotic use in animals is predicted to double by 2030 compared to the last decade.
A recent report exploring the burden of AMR in the Americas in 2019 showed the “multiple realities” of the problem. Not surprisingly, by 2019, the four countries with the lowest AMR-linked mortality rates (age-standardized) each had a financed national action plan to combat AMR, while none of the 10 countries with the highest mortality rates did.
Strikingly, UNICEF reports that more than half of the world’s population does not have access to safe sanitation and over 2.2 billion people still don’t have access to safe drinking water. This is extremely concerning for a variety of reasons, but good sanitation and hygiene is critical to limiting the spread of microbes and reducing the risk of infection.
The current approach taken by most high-income countries is the equivalent of sheltering in the attic, making sure the fire alarm works correctly, while the basement is on fire.
Worldwide spread

Resistant bacteria can evolve anywhere. Even if some countries manage to control the problem within their borders, the risk remains. Resistant bacteria or genes that allow bacteria to grow in the presence of the antibiotic can spread across countries through various means, including travel, immigration, trade and even natural processes like water and air circulation.
Such is the case of the resistance gene NDM-1, which was first described in 2009. Only five years after the initial report, this resistance gene was present in virtually the whole world.
We have all observed the phenomenon of worldwide spread firsthand, as the COVID-19 pandemic vividly demonstrates how pathogens can rapidly traverse the globe.
Communication and collaboration
It is crucial for nations to enhance communication channels and promote education regarding AMR in several sectors, including the general public, health-care providers, farmers and veterinarians. In addition to this, there is a pressing need to establish robust surveillance systems that can promptly detect outbreaks and enable swift action.
Effective cross-border communication could be realized through standardizing surveillance systems. This would enable accurate comparisons of results between countries. Moreover, it facilitates the sharing of valuable resources, equipment, qualified personnel and access to training opportunities.
Both HICs and LMICs should collaborate closely to implement measures aimed at reducing infection rates, such as improved sanitation practices. This collaboration encourages the exchange of knowledge and expertise, enabling the adoption of best practices globally.
The United Kingdom government set a good example in August, when it allocated £210 million (about C$360 million) to tackle AMR across Asia and Africa over the next three years, understanding that this threat cannot be fought from its own trenches. These resources will increase surveillance in 25 countries where the AMR threat is highest, and will also be used to upgrade laboratories and strengthen the health workforce in those countries.
To effectively combat AMR, global co-operation is not a luxury but a necessity. HICs must recognize their responsibility to support LMICs in addressing this crisis. By sharing resources, knowledge and expertise, we can collectively mitigate the threat of AMR.
By safeguarding the effectiveness of antibiotics, we protect ourselves and future generations from the devastating consequences of antimicrobial resistance. Together, we can make a difference in the global fight against superbugs.
Laura Domínguez, Doctoral Researcher and Public Scholar, Biochemistry, Concordia University
Subscribe to our newsletter.
This article is republished from The Conversation under a Creative Commons license. Read the original article.